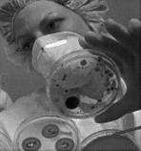

Izrael (652382), страница 2
Текст из файла (страница 2)
Для питьевой воды используют - реку Иордан, пресноводное озеро Киренет и несколько небольших речных водохранилищ. Используются так же водные истоки и подземные воды, содержащиеся на учёте во избежание процесса испарения или избежание осоления воды. Поскольку слишком много источников пресной воды было поражено, пришлось изыскивать другие водные ресурсы за счет очищения отработанных вод, искусственного вызывания осадков и опреснение солёной воды.
Население и культура.
К концу 1991 года в Израиле проживало около 5’000’000 человек. Большинство уроженцев страны,
Стена плача.
остальные приехали из разных стран мира, составив так сказать, живую мозайку из людей различных культур, обычаев и уставов. Еврейское население составляет, почти 4’000’000, не еврейское (большинство арабы) – около 800’000. Образ жизни израильтян различны, от современного до традиционного, от городского до сельского, от коллективного до индивидуального…
Разговорным языком является – иврит.
Более 90% израильтян живут в городах:
Иерусалим – 525’000 человек
Тель-Авив – 340’000 человек
Хайфа – 246’000 человек
Холон – 157’000 человек
Петах-Тиква – 144’000 человек
Бат-Ям – 141‘000 человек
Решон-ле-цион – 140’000 человек
Нетания – 132’000 человек
Беэтр-Шела – 122’000 человек
Мечеть Омара.
Столица Израиля – Иерусалим, считается самым старым городом и представляет собой огромную ценность для верующих людей почти всех религий в мире.
Декларация независимости Израиля гарантирует свободу вероисповеданиям. Каждая община имеет свой религиозный совет и признаваемый закон суд, в юрисдикции которого находится все внутренние дела данной общины и личный статус её членов. Но 850’000 жителей Израиля, или 13,3% население - не евреи.
Арабы – мусульмане, большинство которых суициды, составляют 78% всего нееврейского населения. Большая часть арабов-мусульман живёт в деревнях и небольших городах.
Бедуины – в стране проживает 30 племён, составляющие почти 10% арабского населения Израиля. Сегодня многие бедуины (40% из живущих на юге и 85% живущих на севере) живут в поселениях.
Христиане – 90% которых арабы, являются по численности меньшинством насчитывают около100’000 человек. Они принадлежат к различным конфессиям:
-греко-католическая община (42%)
-греко-православная община (32%)
-римско-католическая община (16%)
б
ольшинство христиан живут в городах: Назарет, Хайфа, Бейт-Шеан.
Храм гроба господня.
Друзы – около 72’000, проживающих в 22 деревнях на севере Израиля, принадлежат к эзотерической общине, существующей в условиях культурной, социальной и религиозной автономии.
Система образования в Израиле.
Образование – один из важнейших ориентиров израильтян. Множес
тво людей – от учащихся дошкольных групп до взрослых граждан – участвуют во всевозможных образовательных программах.
Всеобщее и обязательное школьное обучение охватывает всех детей в возрасте от 6 до 16 лет. Молодые люди в возрасте от 16 до 18 лет продолжают учёбу в зависимости от своего желания и возможностей. Около 90% всех малышей в возрасте от 3 до 4 лет посещают дошкольные детские учреждения.
Главная задача системы образования страны – дать возможность детям, живущим в условиях плюралистического строя, стать ответственными гражданами демократического общества.
В еврейских школах арабский изучают, как второй язык, а иврит – как второй язык – в арабских школах.
В Израиле 8 университетов, 7 религиозных колледжей при университетах, 4 технологических института, 1 институт искусств и 7 учительских колледжей.
Существуют 4 вида школ:
-
государственные
-
средние
-
технологические
-
сельскохозяйственные
Государственные: в которых учатся большинство детей, религиозные государственные школы, в которых акцентируется изучение иудаизма и соблюдения иудейских традиций; арабские и школы друзов, в которых обучение ведется на арабском языке и основное внимание уделяется истории арабов и друзов, их религии и культуре; независимые ультра-ортодассальные еврейские школы, в которых ведётся интенсивное религиозное обучение, для мальчиков и девочек раздельно.
Средние: в некоторых средних школах кроме общеобразовательной программы введены специальные программы с профессиональной ориентацией.
Технологические: дают профессиональную подготовку на трёх условиях: после первого, высшего уровня можно продолжать учёбу в высших учебных заведениях; после второго уровня получают профессиональный диплом, после третьего – приобретаю лишь профессиональные практические повышения. В зависимости от способностей учащиеся могут перейти с 3 или 2 на 1 уровень.
Сельскохозяйственные: расположены обычно рядом с населенным пунктом, сочетают основные предметы обучения с агрономическими дисциплинами. В этих школах поощряется моральные ценности первых поселенцев, вернувшихся на родину предков в начале века.
Военные училища: готовят будущих офицеров и техников в областях, необходимых Армии обороны Израиля. Эти школы – принимают на курс подготовки кадровых офицеров только юношей, а на курс подготовки техников принимают и девушек.
Высшее образование: в систему высшего образования входят университеты, учебные заведения, дающие только степень бакалавра, и университетские курсы в при районных колледжах. Все эти учреждения по закону независимы и принимают тех, кто хочет получить высшие образование.
Высшие учебные заведения находятся в ведении Совета по высшему образованию, который назначается президентом по рекомендации правительства. В состав возглавленного министерством просвещения и культуры Совета входят учёные, представители общественности. Совет уполномочен давать рекомендации правительству по вопросам развития и финансирования высших учебных заведений (получения высшего образования в Израиле платно), а так же научных исследований.
Сегодня около 75’000 студентов учится в университетах, построенных по образцу европейских и американских учебных заведений, но применительно к социально-экономическим, политическим и демографическим изменениям в Израильском обществе и, главным образом, культурным факторам.
Иврит - язык.
Иврит – язык Библии, исторический язык еврейского народа, символ
Элиэзер Бен-Иегуда
его культурного и национального возрождения. На этом языке говорит большинство населения Израиля. В течении многих столетий иврит был лишь языком литературным, еврейской литературы и теологии. В языке сохранилось множество понятий выражающих эмоции и абстрактные мысли. Но вовсе отсутствовали слова современного каждодневного обихода: например, газета, словарь, улица, мостовая, железная дорога., поезд, самолёт, …
С конца 19 века вместе с возрождением еврейской жизни в стране начал возрождаться и иврит, снова становясь разговорным языком. Он является важнейшим средством создания единой нации из еврейских эмигрантов, прибывших в страну со всего мира, средства приобщения их к еврейской традиции и культуре.
Знаете ли Вы, что…
Иврит, на котором не говорили 1700 лет, - единственный мёртвый язык в мировой истории, снова ставший разговорным язык…
Словник иврита возрос примерно с 8’000 слов Библии до 120’000 слов, используемых в наши дни, и всё продолжает расти…
Русский язык позаимствовал много выражений из иврита; среди них такие, как, «козёл отпущения», «семь пар чистых и семь пар нечистых», «казни египетские», и …
Десятки тысяч ивритских слов основываются приблизительно на двухсот корнях, образованных из различных сочетаний трёх букв…
Ивритское слово «амин» проникло сотни языков мира и используется во многих странах чаще, чем любое другое слово…
Элиэзер Бен-Иегуда (1858-1922), основоположник современного разговорного иврита, постоянно обогащал его новыми словами, он же составил первый словарь современного иврита.
Здравоохранение.
Г
лавный принцип системы здравоохранения Израиля – ответственность общества в целом за предоставление медицинской помощи всем его гражданам. Уровень медицинского обслуживания отражается на состоянии здоровья населения. Средняя продолжительность жизни: женщин в Израили –77 лет, мужчин – 73,6 года. Этот показатель –один из самых высоких в мире, тогда как уровень детской смертности - один из самых низких. На 340 жителей страны приходятся 1 врач, а численность врачей – специалистов соответствует уровню самых развитых стран. Население обслуживается широкой сетью медицинских учреждений – 161 больница, 1600 поликлиник и 900 центров матери и ребенка.
О
коло 95% населения страны охвачены разными видами страховых программ, предоставляющих их участникам возможность госпитализации, а также широкий спектр разнообразных медицинских услуг.
Тесное взаимодействие медицинских исследовательских институтов ведет к значительному прогрессу в создании сложного медицинского оборудования.
Образ жизни.
Израиль - страна городская. Около 90% населения проживают в городах и посёлках городского типа. Иерусалим – столица государства, национальный и духовный центр еврейского народа. Исторические и археологические источники относят его основание к 1000 до н.э. Тель-Авив индустриальный, коммерческий, финансовый и культурный цент страны – основан в 1909 году как первый современный еврейский город. Хайфа – главный порт на севере страны. Такие города, как Иерусалим, Пеэр-Шева, Назарет, Акко, Цфат, Ашкелон имеют древнюю историю и сохраняют свои прежние названия. Другие возникли как сельские населения и постепенно стали городами. Это – Реховот, Петах-Тиква, Хадера. А города Арад и Кармиель были построены, чтобы обеспечить жильём население, стремительно возросли в результате массовой эмиграции.
Внешняя и внутренняя политика.
Демократия.
И
зраиль – страна парламентской демократии, состоящей из трёх основных звеньев: законодательная и
Кнессет.
исполнительная власть, а так же судебная система. Исполнительная власть (правительство) находится под контролем Кнессета (израильского парламента), осуществляющегося законодательную власть. Абсолютная независимость судебной системы гарантируется законодательством страны. Главой государства является – президент. Основная задача президента – обеспечить единство и стабильность государства. Президент стоит над партиями и осуществляет свою власть вне зависимости от той или иной партийной политики. На всеобщих, тайных и пропорциональных выборах каждые 4 года избирается 120 членов Кнессета. До сих пор ни одна партия не сумела получить достаточного числа мест в Кнессете, чтобы иметь возможность сформировать однопартийное правительство. Поэтому Израиль управляется коалицией, состоящей из 2ух и более партий.
Свобода печати – основополагающий принцип израильской демократии, так же, как свобода слова и собраний. Все израильские граждане равны перед закон и имеют одни и те же права. В Израиле 40 муниципалитетов, в том числе 3 арабских, 137 местных советов, в том числе 60 арабских и 54 религиозных совета, в том числе 1 друзский. Муниципальные и местные советы избираются на выборах в соответствии с принципами пропорционального представительства (как и на выборах в Кнессет), тогда как
Заседание Кнессета.
мэры и главы местных советов избираются прямым голосованием, а главы региональных советов избираются из состава председателей всех сельских и городских советов региона.
Постоянные жители, не являющиеся избирательскими гражданами, также имеют право участвовать в муниципальных выборах.
Алия.
Воссоединение изгнанников – возращение евреев на их древнюю родину после многих веков рассеяния – один из основополагающих принципов создания и развития государства Израиль. В годы, предшествование созданию государства, большинство евреев прибывало из Европы. Вскоре после провозглашения независимости народонаселения удвоилось благодаря прибытию уцелевших от Катастрофы европейских евреев и евреев из арабских стран. С тех пор репатрианты продолжали прибывать в Израиль со всего света. За последние годы в страну приехали тысячи представителей древней европейской общины. Вследствие резких изменений политической ситуации в государствах Восточной Европы открылась возможность массовой эмиграции евреев из этих стран. С каждым днём растёт новая волна алии – в основном из стран бывшего СССР. Большинство эмигрантов предпочитают селиться в крупных городах страны.